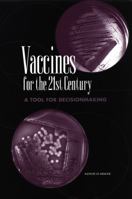
Vaccines for the 21st Century: A Tool for Decisionmaking 0309056462 Book Cover

- Extending Life, Enhancing Life: A National Research Agenda on Aging
- Medical Professional Liability and the Delivery of Obstetrical Care: Volume II, An Interdisciplinary Review (Medical Professional Liability & the Delivery of Obstetrical)
- Preventing Low Birthweight
- Second Fifty Years
- Veterans and Agent Oran Herbicide/Dioxin Exposure and Acute Myelogenous Leukemia in the Children of Vietnam Veterans